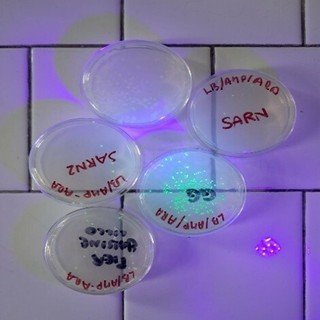
La scienza prende vita nei laboratori del Liceo Giolitti-Gandino di Bra

24 Ore
mercoledì 18 febbraio
Allerta gialla in Piemonte per neve a bassa quota e rischio valanghe: domani fiocchi fino in pianura
15:27
A Cherasco il Duo Platini in concerto per la rassegna "D'Accordi Musicali" suona "Il flauto magico"
14:50
Archivio 24 Ore
giovedì 19 febbraio
mercoledì 18 febbraio